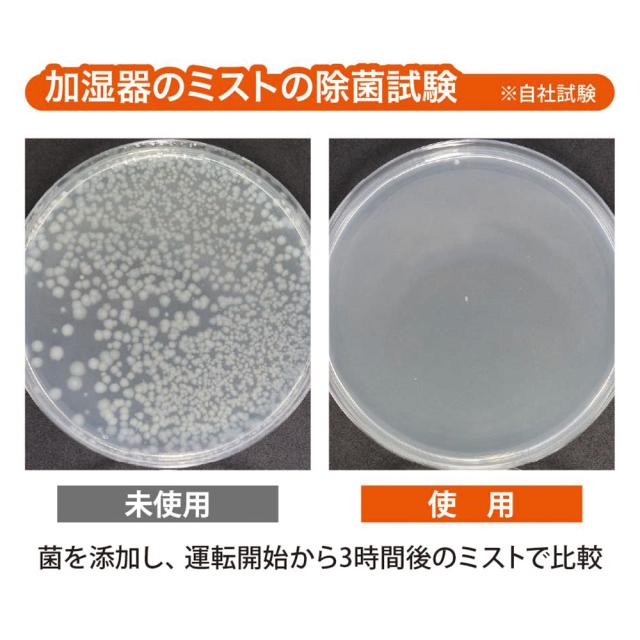

ビッグバイオ 加湿器 除菌 メンテ 自然由来成分 ヌメリ予防 カルキ対策 かんたん入れるだけ 日本製 加湿器さぷり 60錠入
Pontaパス特典
サンキュー配送
968円(税込)
0ポイント(1%)
商品説明

タンク内からミストまで キレイをサポート
アミノ酸+ビタミンC配合 除菌、ヌメリ予防、カルキ対策に!
抗菌性アミノ酸とは…
微生物による発酵で生産される天然保存料です。試験により高い安全性が確認されており、お弁当やお惣菜、お菓子の保存料など幅広く使用されています。
カルキ対策にビタミンC
水道水などに含まれるカルキを中和。カルキ汚れをつきにくくします。
●抗菌性アミノ酸とビタミンCのチカラで加湿器や空気清浄機のタンクを除菌し清潔を保ちます。
●カルキ対策ができ、メンテナンスの煩わしさを軽減します。
●食品素材からできているので安心してお使いいただけます。
●錠剤タイプだから小さい給水口でも入れやすいです。
●年中使用するアロマディフューザーにも使用できます。
●錠剤だから持ち運びも、ホテルなどの外泊先でも
●使い方は、かんたん。タンク給水時に錠剤を入れるだけ
<対応機種>給水タンクのある加湿器
空気清浄機能がついた加湿器、ペットボトルに取り付ける加湿器にも使用OK。
アミノ酸+ビタミンC配合 除菌、ヌメリ予防、カルキ対策に!
抗菌性アミノ酸とは…
微生物による発酵で生産される天然保存料です。試験により高い安全性が確認されており、お弁当やお惣菜、お菓子の保存料など幅広く使用されています。
カルキ対策にビタミンC
水道水などに含まれるカルキを中和。カルキ汚れをつきにくくします。
●抗菌性アミノ酸とビタミンCのチカラで加湿器や空気清浄機のタンクを除菌し清潔を保ちます。
●カルキ対策ができ、メンテナンスの煩わしさを軽減します。
●食品素材からできているので安心してお使いいただけます。
●錠剤タイプだから小さい給水口でも入れやすいです。
●年中使用するアロマディフューザーにも使用できます。
●錠剤だから持ち運びも、ホテルなどの外泊先でも
●使い方は、かんたん。タンク給水時に錠剤を入れるだけ
<対応機種>給水タンクのある加湿器
空気清浄機能がついた加湿器、ペットボトルに取り付ける加湿器にも使用OK。
商品スペック
■成分:抗菌性アミノ酸重合体、ビタミンC、有機酸炭酸ナトリウム、炭酸水素ナトリウム、賦刑剤■内容量:60錠■保存期限:2年■原産国:日本
レビュー
商品の評価:



 -点(0件)
-点(0件)
お店の情報
お店の評価:



 -点(0件)
-点(0件)
連絡・応対
-
配送スピード
-
梱包
-









